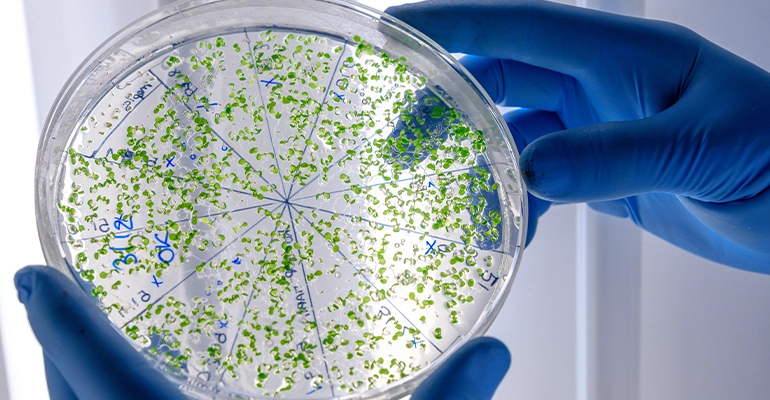
Autologous Stem Cell Hair Treatment

Autologous Stem Cell Hair Treatment
Autologous Stem Cell Hair Treatment is an advanced regenerative therapy offered at Merve Kaya Hair Transplant that harnesses the body’s own healing potential to restore and strengthen hair. This innovative treatment uses stem cells derived from the patient’s own tissue to stimulate natural follicle regeneration, enhance blood circulation, and improve scalp vitality — all without surgery or artificial substances. It is one of the most effective biological approaches to preventing hair loss and promoting long-term growth.
What Is Autologous Stem Cell Hair Therapy?
The word “autologous” means that the stem cells come entirely from the patient’s own body. In this treatment, a small amount of tissue or fat is collected through a minimally invasive process. The sample is then processed to isolate stem cells and bioactive growth factors, which are injected directly into the scalp. These stem cells communicate with existing follicles and skin cells, triggering repair, regeneration, and new hair production. Because the cells are naturally compatible with the body, the treatment is completely safe and free from allergic reactions.
How Stem Cells Help Revitalize Hair Follicles
Stem cells are undifferentiated cells with the ability to transform into other cell types. When introduced into the scalp, they release growth factors and signaling molecules that reactivate dormant follicles and repair damaged tissue. This process increases microcirculation, improves oxygen supply, and enhances the scalp’s biological environment. Over time, patients experience thicker, denser, and stronger hair growth — even in areas affected by chronic thinning or hormonal loss.
The Procedure: Step by Step
- Sample collection: A small tissue or fat sample is taken under local anesthesia in a quick, painless procedure.
- Cell isolation: The sample is processed in a sterile environment to extract stem cells and regenerative factors.
- Preparation: The stem cell concentrate is combined with PRP (Platelet-Rich Plasma) or exosome-rich serum for enhanced regeneration.
- Application: The solution is injected into the scalp with micro-needling or fine needles, targeting areas of thinning or loss.
Key Benefits of Autologous Stem Cell Hair Treatment
- Completely natural: Uses the patient’s own cells — no synthetic chemicals or artificial implants.
- Effective follicle activation: Stimulates dormant follicles and promotes natural regrowth.
- Improved hair density: Strengthens existing strands and thickens overall hair volume.
- Safe and biocompatible: No risk of immune reaction or rejection since it’s derived from your own tissue.
- Accelerated healing: Reduces inflammation, improves scalp texture, and shortens recovery time.
- Long-term benefits: Continuous improvement in hair quality for several months after treatment.
Who Can Benefit from This Therapy?
Autologous Stem Cell Hair Treatment is ideal for both men and women experiencing early to moderate hair loss, thinning, or weakened follicles. It can also be used to improve the outcomes of surgical hair transplants such as FUE or DHI, enhancing graft survival and accelerating healing. Patients suffering from stress-induced, hormonal, or hereditary hair loss often see visible improvement in both hair growth and scalp health.
Why Choose Merve Kaya Hair Transplant?
Merve Kaya Hair Transplant is a leader in regenerative hair medicine, offering advanced biological therapies that merge science with aesthetics. Every Autologous Stem Cell Hair Treatment is performed in a controlled clinical environment by experts specializing in regenerative procedures. The clinic integrates this therapy with supportive treatments such as PRP and Exosome infusions to maximize follicle activation and scalp renewal. By focusing on cellular repair and biological balance, Merve Kaya Hair Transplant provides a truly natural and long-lasting solution for healthier, str





